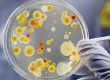

چهار راه طالقانی کرج قلب پزشکی و درمانی شهر کرج به حساب می آید و شما در این منطقه انواع خدمات پزشکی و درمانی را میتوانید دریافت کنید. یکی از خدماتی که در کنار تشخیص ها و درمان های پزشکی به آن نیاز است، تست های آزمایشگاهی هست.
دلیل اصلی استقرار آزمایشگاه چکاپ در این منطقه، سهولت دسترسی افراد به آزمایشگاه در کنار سایر خدمات پزشکی و درمانی بوده است.
آزمایشگاه چکاپ یکی از مجهزترین آزمایشگاه چهار راه طالقانی کرج بوده و با امکانات مختلف آزمایشگاه خون شناسی، هورمون شناسی، بیوشیمی، میکروبیولوژی، سرولوژی و … و با دارا بودن تجهیزات پیشرفته آنالیز خون و دستگاه فلوسایتومتری خدماتی منحصر به فرد را در منطقه به مراجعین محترم ارائه میکند.
برای دسترسی به آزمایشگاه چکاپ کافی است به چهار راه طالقانی کرج مراجعه کرده و چند قدم در طالقانی جنوبی به جلو حرکت کنید. آزمایشگاه چکاپ در کنار پارکینگ طبقاتی طالقانی قرار گرفته است و در صورتی که با خودرو به محل آزمایشگاه مراجعه میکنید، کافی است خودرو خود را در پارکینگ طالقانی پارک کرده و 50 متر به سمت چهار راه طالقانی به جلو حرکت کنید.